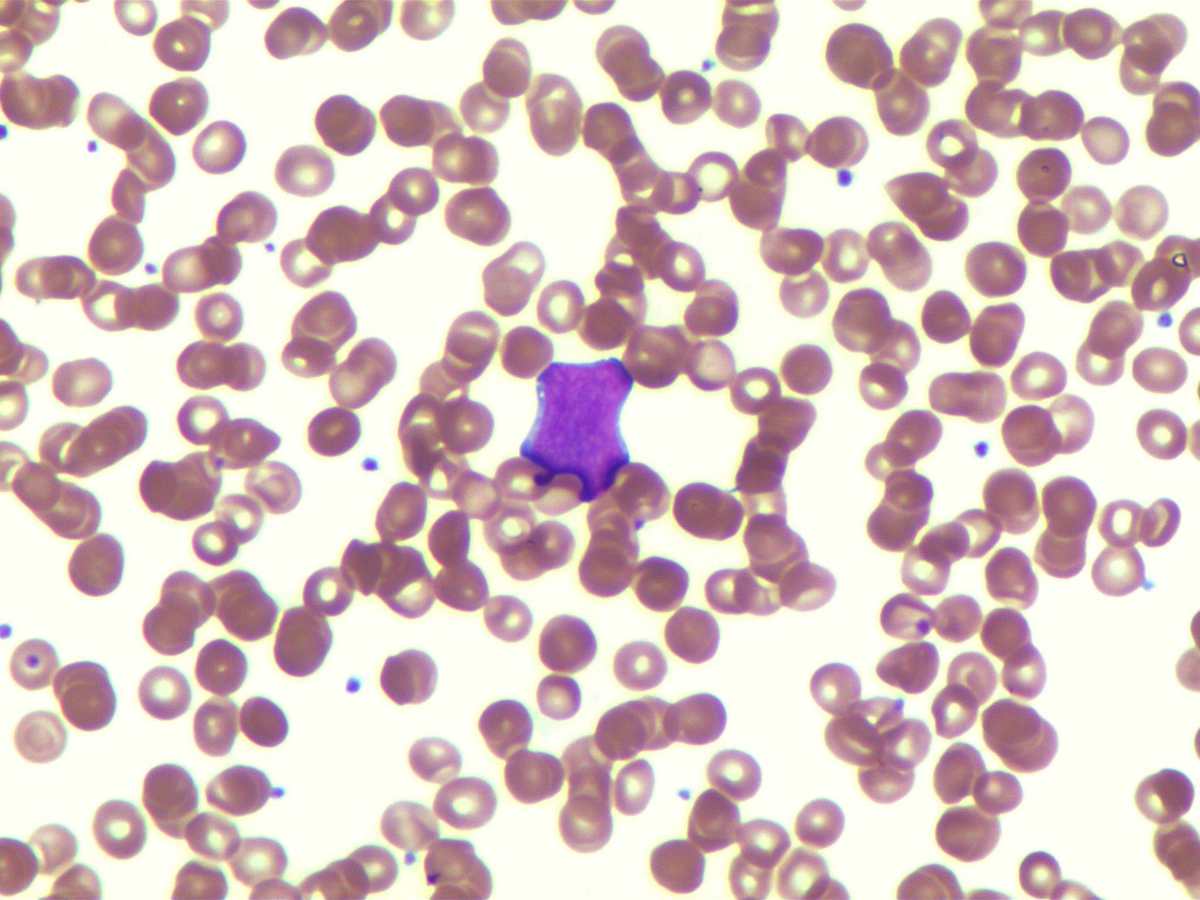
Rare blasts in peripheral blood
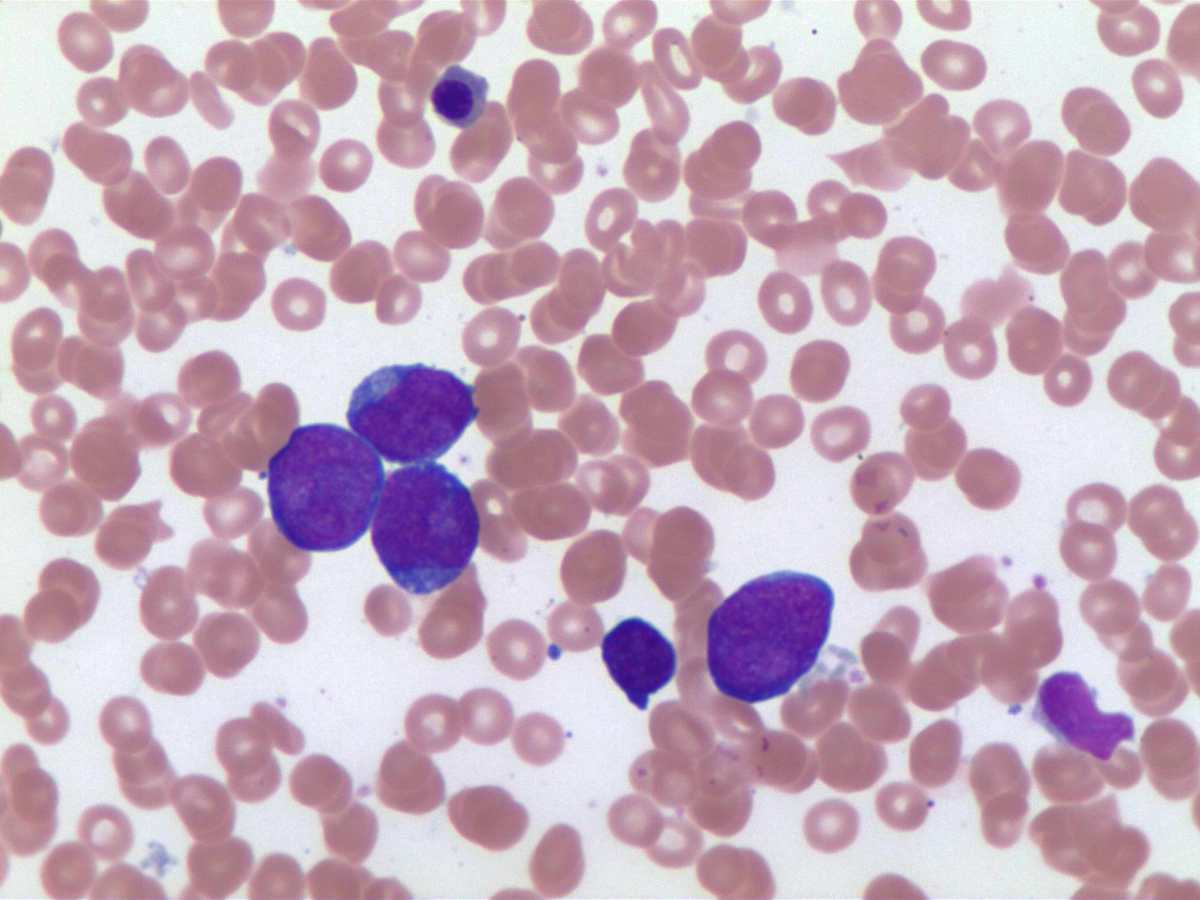
Blasts in bone marrow aspirate 60x
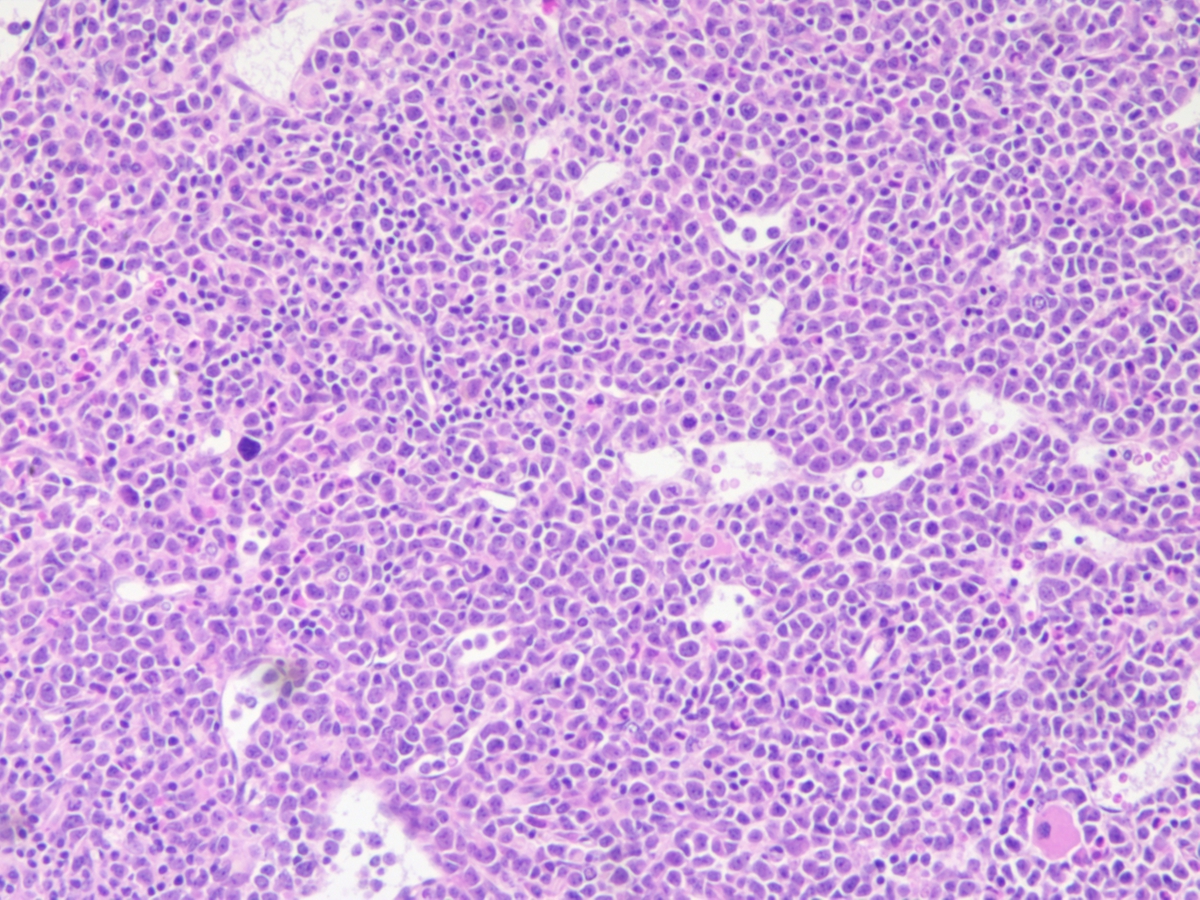
Bone marrow biopsy 10x

Institution: Kingston General Hospital, Queen's University
Additional authors:Michael Rauh, MD, FRCPC
Session: AML with recurrent genetic abnormalities Part I
HISTORY
56 year old female with past history of hyperthyroidism, hyperlipidemia and recurrent sinusitis. She was referred to a hematologist for evaluation of normocytic anemia. She had been previous feeling tired and unwell following an upper respiratory tract infection, was found to be significantly anemic and was transfused with three units of packed red cells. She also developed transient neutropenia that resolved by the time of the hematology visit. After followup for another month and requirement for another red cell transfusion, a bone marrow examination was performed.
DETAILS
Bone marrow aspirate and biopsy performed from posterior iliac crest, site not specified. Bone marrow biopsy fixed in AZF, decalcified in RDO.
The peripheral blood film revealed a rare circulating blast and occasional partially degranulated basophils but with no absolute basophilia.The bone marrow aspirate was dilute and partially clotted but was hypercellular for age. 40% blasts were enumerated, with their morphological appearance being large with irregular nuclei, fine chromatin, occasional large nucleoli and small amounts of basophilic cytoplasm. Occasional granules were noted but no Auer rods were seen. A few degranulated basophils were also observed, similar to the peripheral blood. Erythropoiesis was markedly reduced with a mild reduction in megakaryocytes.The bone marrow biopsy was approaching 100% cellularity with sheets of immature mononuclear cells and scattered mitotic figures, representing blasts and left shifted myeloid cells. Erythropoiesis was markedly reduced with scattered unremarkable megakaryocytes. A couple of interstitial lymphoid aggregates were present in close association with small blood vessels, suggesting reactive aggregates.IMMUNOHISTOCHEMISTRY AND FLOW CYTOMETRY
Flow cytometry performed on the bone marrow aspirate revealed 30% blasts expressing CD34, CD117, CD33, CD11b and HLA-DR with partial expression of myeloperoxidase and the T cell markers CD4 and CD7. Of note, the blasts were negative for CD19, CD10, cytoplasmic CD3 and CD79a. Analysis of the lymphoid region revealed mainly T cells with 10% polytypic B cells.
Immunohistochemistry performed on the bone marrow biopsy revealed that the lymphoid aggregates were a mixture of CD3+ T cells and CD20+ B cells with T cells predominating. There was no coexpression of CD5 or CD10 on the B cells.CYTOGENETIC FINDINGS
Cytogenetics:
56XX,+2,+6,+8,+9,t(9;22)(q34.1;q11)x2,+11,+12,+19,+20,+21,+22[10]Metaphase FISH:Dual FISH probes for BCR/ABL1 at 22q11.2 and 9q34 respectively and the ASS locus mapping to 9q34 revealed an abnormal signal pattern consistent with t(9;22)(q34;q11.2) and confirmed the presence of the BCR/ABL1 fusion gene on both derivative 22 chromosomes.Interphase FISH:Dual FISH probe for BCR/ABL1 at 22q11.2 and 9q34 respectively. 233 interphase nuclei were examined with 96 (47%) showing 4 BCR/ABL1 fusion signals.MOLECULAR FINDINGS
PCR analysis of the IGH gene was negative for a clonal B cell population.
INTERESTING FEATURES
This is an unusual presentation for a Philadelphia positive AML with no antecedent history of CML. It was a rather innocuous history with only recent transfusion dependent anemia. As well, hyperdiploidy is a rare finding in myeloid malignancies as it is more commonly associated with ALL. However, the presence of high hyperdiploidy (>49 chromosomes) in combination with t(9;22) has been reported in the literature in the context of AML.
PROPOSED DIAGNOSIS
Acute myeloid leukemia, not otherwise specified with presence of t(9;22)(q34;q11.2) and hyperdiploidy.
CONSENSUS DIAGNOSIS
Acute myeloid leukemia with t(9;22)(q34;q11.2); BCR-ABL1, and hyperdiploidy
| Rare blasts in peripheral blood | |
| Blasts in bone marrow aspirate |  |
| Blasts in bone marrow aspirate 60x | |
| Blasts in bone marrow aspirate |  |
| Bone marrow biopsy 2x |  |
| Bone marrow biopsy 10x | |
| Bone marrow biopsy, lymphoid collection |  |
| Bone marrow biopsy 60x |  |
| Bone marrow biopsy CD34 |  |
| Bone marrow biopsy CD3 |  |
| Bone marrow biopsy CD20 |  |